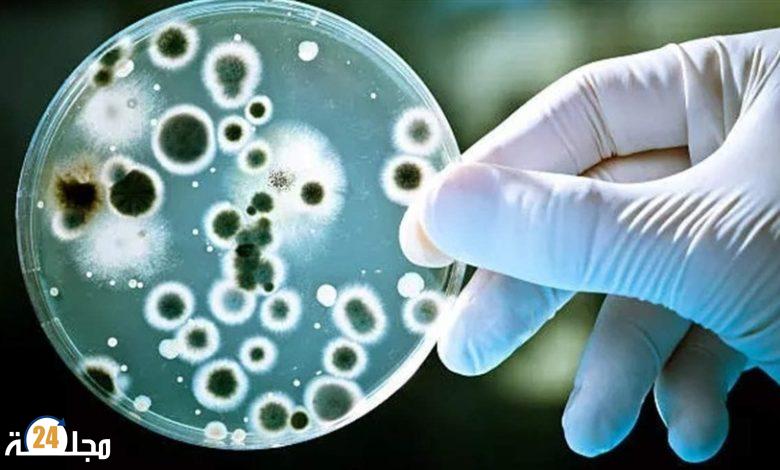
اكتشاف بكتيريا مقاومة للمضادات الحيوية

اكتشاف بكتيريا مقاومة للمضادات الحيوية
اكتُشفت في الغيوم بكتيريا مقاومة للمضادات الحيوية سحبتها الرياح إلى السحاب لمسافات طويلة جداً أحياناً، على ما كشفت دراسة فرنسية كندية.
وقال معد الدراسة الرئيسي فلوران روسّي إنّ “هذه البكتيريا عادة ما تعيش فوق الأوراق أو داخل التربة”، بحسب وكالة فرانس برس.
ونقلت الوكالة عن روسي قوله “اكتشفنا أنّ الرياح حملتها إلى الغلاف الجوي، وأنّ بإمكانها التنقل لمسافات طويلة وعبور الكرة الأرضية على ارتفاعات عالية بفضل السحب”.
وكان عدد من الباحثين في جامعة لافال في كيبيك وجامعة كليرمون أوفيرنيه قد أخذوا عينات باستخدام “مكانس كهربائية” عالية السرعة من سحب متشكّلة فوق بوي دو دوم، وهو بركان خامد في وسط فرنسا، بين سبتمبر 2019 وأكتوبر 2021.
ومن محطة أبحاث تقع على ارتفاع 1465 متراً، حلّل العلماء هذه العينات بحثاً عن جينات مقاومة للمضادات الحيوية.
وقد توصّلوا إلى أنّ الغيوم احتوت على ما بين 330 وأكثر من 33 ألف بكتيريا لكل مليلتر من الماء، في متوسط نحو 8 آلاف بكتيريا لكل مليلتر. وتم تحديد 29 نوعاً فرعياً من الجينات المقاومة للمضادات الحيوية في البكتيريا.
ومع شيوع استخدام المضادات الحيوية في الرعاية الصحية والمجال الزراعي، يمثل هذا النوع من البكتيريا “تحدياً صحياً كبيراً على المستوى العالمي”، بحسب الدراسة.
وكانت السلطات الصحية العالمية أشارت مرات عدة إلى أخطار هذه البكتيريا التي تعقّد بصورة متزايدة معالجة بعض أنواع الأمراض.
إلا أنّ الدراسة، التي نشرت في عدد مارس من مجلة “ساينس أوف ذي توتال إنفايرنمنت”، لم تقدم أي استنتاجات في شأن الآثار الصحية المُحتمل تسجيلها لانتشار بكتيريا تحمل جينات مقاومة للمضادات الحيوية في الأجواء، مشيرة إلى أنّ 5 إلى 50 % فقط من هذه الكائنات قد تكون على قيد الحياة ويُحتمل أن تكون نشطة.
وقال روسّي إنّ “الغلاف الجوي قاسٍ جداً على البكتيريا”، مضيفاً أن معظم البكتيريا التي اكتشفناها كانت بيئية”، ومن غير المُحتمل أن تكون ضارة للإنسان.

